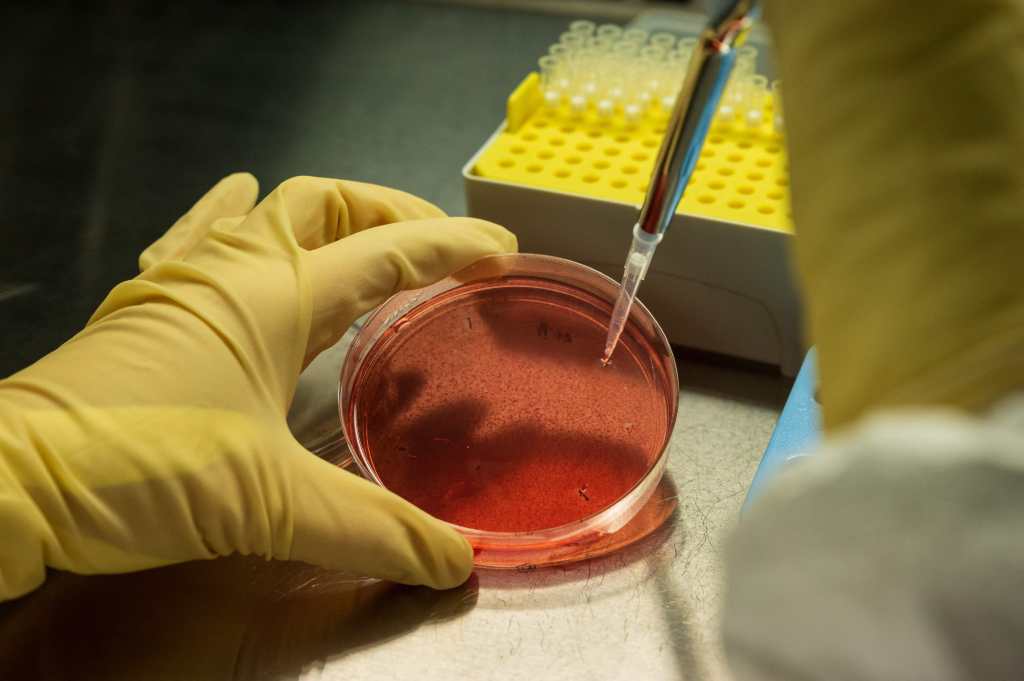

Mediante el uso de una técnica que los investigadores llaman código de barras, se ha descubierto una respuesta inesperada para este misterio: el tratamiento no siempre se dirige a las células correctas.
Los científicos descubrieron que, en ocasiones, el cáncer no se origina en las células maduras de la médula ósea donde se encuentra y donde la literatura dice que se origina. Más bien, en algunos pacientes, el origen del cáncer puede ser en las células primitivas de la médula ósea, las células madre, que producen todos los glóbulos blancos y rojos del cuerpo. Esas células, sobre las cuales no tiene efecto el tratamiento con quimioterapia, pueden generar nuevas células cancerosas, lo que provoca una recaída.
Este descubrimiento es un producto inicial del método de código de barras, el cual está ayudando al estudio sobre el origen del cáncer y de otras enfermedades. Los resultados son demasiado nuevos como para haber desarrollado terapias para los pacientes. Pero son fuente de descubrimientos estimulantes que se esperan que puedan incentivar a la creación de métodos novedosos para tratar las enfermedades.
Mediante este método, se marcan las células individuales con un sello que se transmite a toda la descendencia de una célula. Los investigadores pueden ver una célula, observar su código de barras y rastrear su ascendencia hasta sus padres, abuelos, bisabuelos —y así hasta sus orígenes— porque todas las células que surgieron de la célula original con código de barras tienen el mismo sello.
La idea del código de barras durante el desarrollo embrionario se originó con Jay Shendure y sus colegas en la Universidad de Washington, y la revista Science nombró a este tipo de métodos la innovación del año en 2018. Ahora existe una variedad de métodos para aplicar el código de barras que va desde las células embrionarias hasta las células maduras pasando por las células cancerosas.
Por ejemplo, Shendure y otro grupo de colegas de la Universidad de Pensilvania están usando los códigos de barras en ratones con cáncer de páncreas para estudiar la propagación de las células cancerosas en su cuerpo.
En el caso del LLC, Vijay Sankaran, del Hospital Infantil de Boston, y sus colegas aplicaron un código de barras a las células cancerosas humanas aprovechando las mutaciones inocuas que ocurren de manera natural y que marcan las células individuales y son heredadas por su descendencia.
Sankaran comentó que el código de barras “está comenzando a darnos un panorama que jamás habíamos visto acerca del cáncer”.
Estas técnicas también revelaron un resultado sorprendente para Leonard Zon, de la Escuela de Medicina de la Universidad de Harvard. Zon quería estudiar la hematopoyesis clonal de potencial indeterminado, o HCPI, una enfermedad común, pero no muy comprendida que por lo general se presenta en las personas mayores y aumenta el riesgo de cáncer y cardiopatías. La HCPI aparece cuando la descendencia de una sola célula madre de la sangre toma el control de toda la médula ósea o gran parte de ella y expulsa a otras células madre.
Con el fin de investigar esto, Zon marcó células madre individuales de la médula con diferentes colores en pececitos cebra transparentes. El resultado fue parecido a lo que ocurre en los pacientes: para cuando los peces eran adultos, la mitad de sus glóbulos eran de un solo color. Lo que significaba que provenían de una sola célula madre.
¿Pero cómo llegó a tomar el control una célula?
La respuesta resultó sorpresiva. Las células predominantes secretaban proteínas tóxicas inflamatorias. Esas proteínas inhibían el crecimiento de otras células madre y dañaban el ambiente donde crecen las células de la médula. Pero las células madre progenitoras sobrevivían y seguían generando nuevas células descendientes secretoras de toxinas.
El equipo también descubrió un gen en las células mutantes que las hacía resistentes a la inflamación. Cuando bloqueaban ese gen, las células mutantes ya no podían tomar el control.
Fernando Camargo, un biólogo especialista en células madre del Hospital Infantil de Boston, abordó un problema diferente: ¿por qué son tan difíciles los tratamientos comunes contra el cáncer que consisten en el trasplante de células madre sanas de la médula ósea de donantes y que a menudo dejan a los pacientes vulnerables a infecciones graves?
Cuando Camargo y sus colegas aplicaron códigos de barras a las células de los ratones marcándolas en los genes con la técnica de edición de genes conocida como CRISPR (‘Clustered Regularly Interspaced Short Palindromic Repeats’, o repeticiones palindrómicas cortas, agrupadas y regularmente interespaciadas), descubrieron que las células a las que todos llamaban células madre no eran las principales participantes en la producción de sangre.
“Siempre supusimos que esas eran las mismas células que casi siempre dan origen a toda la sangre”, señaló Camargo.
Más bien, un conjunto diferente de células, que él llama células progenitoras, produce la mayor parte de la sangre en los animales vivos. En un trasplante de célula madre, se trasplantan tanto las células progenitoras como las células madre putativas, pero las células progenitoras mueren con rapidez en el nuevo ambiente.
Ahora la pregunta es: ¿por qué las células progenitoras no sobreviven al trasplante? Tal vez porque la fuerte dosis de radiación y quimioterapia que limpia la médula para el trasplante hacen que esta se vuelva inhóspita. O quizás las células progenitoras, inyectadas a la sangre con las células madre, no pueden encontrar su camino hacia la médula.
Camargo se queda pensativo.
“Creíamos que sabíamos todo sobre las células madre de la sangre”, comentó. “Es evidente que no era así”.
Un par de fotografías sin fecha proporcionadas por el Instituto de Células Madre de la Universidad de Harvard, muestran cómo los colores inconfundibles de los peces cebra sirven como códigos de barras que reflejan la producción de células madre individuales de la sangre. En los peces cebra normales, la sangre es de varios colores porque muchas células madre participan en la producción de la sangre. En la hematopoyesis clonal, predomina un solo clon, y por lo tanto un solo color. (Harvard Stem Cell Institute)